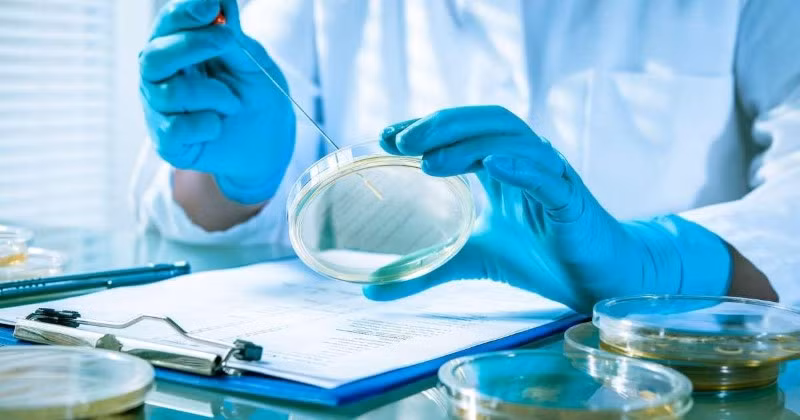
Vi khuẩn “nhớ” quá khứ

Để ghi lại những "ký ức" này, vi khuẩn sử dụng điện thế màng (membrane potencial) – thứ điện thế giữ vai trò quan trọng trong hình thành dấu vết ký ức ở con người.
Trí nhớ là khả năng khá phức tạp, đòi hỏi phải được ghi nhận, lưu trữ, sau đó tái tạo các thông tin hoặc cảm xúc. Cho đến nay, người ta cho rằng, chỉ có các sinh vật đa bào, phức tạp mới có khả năng ghi nhớ. Trong khi đó, thực tế cho thấy, vi khuẩn cũng có một kiểu trí nhớ. "Trong nghiên cứu mới nhất, chúng tôi chứng minh rằng các sinh vật bề ngoài tưởng chừng đơn giản, chẳng hạn như vi khuẩn, cũng có thể "nhớ" sự kiện từ quá khứ - khả năng đó, cho đến nay, được xem là đặc điểm của nơron", nữ Tiến sĩ Maja Białecka-Fornal ở ĐH California (Mỹ), cho biết như vậy.
"Những vi khuẩn được tiếp xúc với ánh sáng xanh trong thời gian ngắn phản ứng với các nhiễu loạn bên ngoài khác với các vi khuẩn không được kích thích bằng ánh sáng xanh. Thêm vào đó, hiệu ứng này còn được duy trì trong vài ba giờ sau đó" – bà Białecka-Fornal giải thích.
Theo Tiến sĩ Maja Białecka-Fornal, điều đó chứng tỏ rằng, các vi khuẩn lưu giữ thông tin về những sự kiện xảy ra trong quá khứ. Hơn nữa, quá trình "nhớ" này diễn ra ở mức điện thế màng (chênh lệch điện thế giữa hai phía của màng tế bào) – thứ điện thế đóng vai trò quan trọng trong hình thành các dấu vết trí nhớ trong não.
"Trong nghiên cứu mới nhất, chúng tôi chứng minh được rằng, các tế bào "phơi" dưới ánh sáng xanh có mức độ hoạt động của kênh ion (protein màng, cho phép các ion đi qua màng tế bào) khác hẳn. Tương tự như trường hợp các nơron với hoạt tính phụ thuộc vào lưu lượng điện tích qua các kênh ion" – bà Białecka-Fornal nói.
Cùng các đồng nghiệp, Tiến sĩ Białecka-Fornal quyết định nghiên cứu "trí nhớ" của vi khuẩn sau khi phát hiện ra rằng vi khuẩn có thể giao tiếp với nhau các trong màng sinh học (nhóm các vi khuẩn dính với nhau) thông qua việc sử dụng các kênh ion. Trước đó, các nhà nghiên cứu cũng nghi ngờ rằng cách mà vi khuẩn phản ứng, phụ thuộc vào trạng thái mà trước đó chúng đã ở trong. "Điều này cũng tương tự như hiện tượng hoạt động của nơron trong quá khứ có thể ảnh hưởng đến mức độ hoạt động trong tương lai", Tiến sĩ Białecka-Fornal cho biết.
Các nhà nghiên cứu có thể trực tiếp quan sát các vi khuẩn có khả năng "nhớ" các rối loạn từ quá khứ và so sánh phản ứng của chúng với các vi khuẩn khác trên cùng màng sinh học nhưng không được kích thích bằng ánh sáng xanh.
"Có khá nhiều cách ứng dụng phát hiện của chúng tôi. Một trong những cách đó là nghiên cứu nguồn gốc trí nhớ và hiểu sâu thêm về các đường dẫn làm hình thành nơron. Cũng có thể sử dụng mô hình đơn giản của chúng tôi để nghiên cứu đặc tính trí nhớ được mã hóa ở mức điện thế màng. Chúng tôi tin rằng phát hiện của mình là bước tiến đầu tiên để tạo ra máy tính sinh học" – bà Białecka-Fornal cho biết.